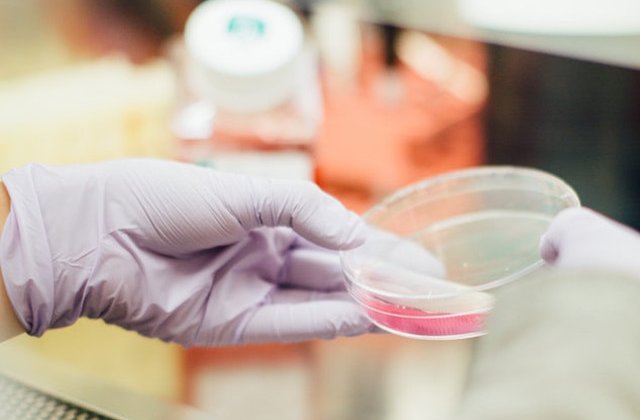
Doi elevi din SUA au fost atacati cu o substanta chimica periculoasa

Vinovatul ar fi un elev in varsta de 16 ani, care a aruncat cu subtanta chimica asupra celor doi colegi, unul de 14, altul de 16 ani.
Politistii au intervenit, intrucat cei doi baieti au suferit arsuri grave, in special la nivelul fetei, potrivit Stirileprotv.
Atacatorul a fost retinut de politisti, care au deschis o ancheta ce va stabili identitatea substantei chimice folosite.
Despre autor:
Te-ar putea interesa si:
In lipsa unui acord scris din partea Internet Corp, puteti prelua maxim 500 de caractere din acest articol daca precizati sursa si daca inserati vizibil linkul articolului.
Mai multe despre
-

Ce planuri are PKO Bank în România: cea mai mare bancă din Polonia are active...
Sursa: futurebanking.ro
-

Sumă record cheltuită de utilizatorii OnlyFans în 2024. Câți bani au ajuns la...
Sursa: wall-street.ro
-

ANALIZĂ VIDEO Primele produse tehnologice sunt mai mereu proaste
Sursa: start-up.ro
-

Paște 2026: cât costă un cozonac plin cu de toate, în București
Sursa: retail.ro
-

Cine sunt speakerii Green Forum 2026: Cum finanțăm?
Sursa: green.start-up.ro
-

Cremă de față cu SPF făcută acasă: până la 30% mai puține ingrediente...
Sursa: garbo.ro
-

Prima mare surpriză a Mondialului!
Sursa: kudika.ro